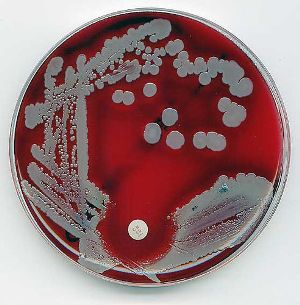

Microbiology and Forensics
by Samkelisiwe Nkosi
(Durban, South Africa)

Photo Credit: Estherese
I am currently studying microbiology and would like to know if I would be hired in a forensic industry.
by Samkelisiwe Nkosi
(Durban, South Africa)
Photo Credit: Estherese
I am currently studying microbiology and would like to know if I would be hired in a forensic industry.